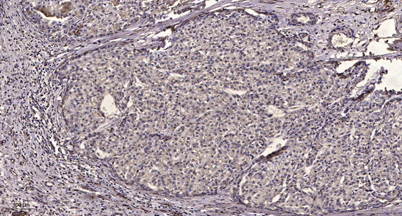

PDGF Receptor β (phospho-Tyr1009) rabbit pAb
 One-click to copy product information
One-click to copy product information$148.00/50µL $248.00/100µL
| 50 µL | $148.00 |
| 100 µL | $248.00 |
Overview
| Product name: | PDGF Receptor β (phospho-Tyr1009) rabbit pAb |
| Reactivity: | Human;Mouse |
| Alternative Names: | Platelet-derived growth factor receptor alpha (PDGF-R-alpha) (PDGFR-alpha) (EC 2.7.10.1) (Alpha platelet-derived growth factor receptor) (Alpha-type platelet-derived growth factor receptor) (CD140 antigen-like family member A) (CD140a antigen) (Platelet-derived growth factor alpha receptor) (Platelet-derived growth factor receptor 2) (PDGFR-2) (CD antigen CD140a) |
| Source: | Rabbit |
| Dilutions: | WB 1:500-2000;IHC-p 1:50-300 |
| Immunogen: | Synthesized phosho peptide around human PDGF Receptor β (Tyr1009) |
| Storage: | -20°C/1 year |
| Clonality: | Polyclonal |
| Isotype: | IgG |
| Concentration: | 1 mg/ml |
| Observed Band: | 180kD |
| GeneID: | 5156 |
| Human Swiss-Prot No: | P16234 |
| Cellular localization: | Cell membrane ; Single-pass type I membrane protein . Cell projection, cilium . Golgi apparatus . |
| Background: | This gene encodes a cell surface tyrosine kinase receptor for members of the platelet-derived growth factor family. These growth factors are mitogens for cells of mesenchymal origin. The identity of the growth factor bound to a receptor monomer determines whether the functional receptor is a homodimer or a heterodimer, composed of both platelet-derived growth factor receptor alpha and beta polypeptides. Studies suggest that this gene plays a role in organ development, wound healing, and tumor progression. Mutations in this gene have been associated with idiopathic hypereosinophilic syndrome, somatic and familial gastrointestinal stromal tumors, and a variety of other cancers. [provided by RefSeq, Mar 2012], |

 Manual
Manual